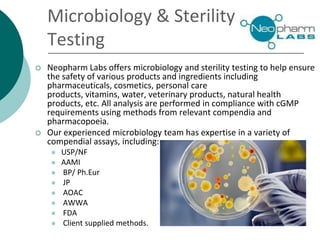
Microbiology & Sterility
Testing
 Neopharm Labs offers microbiology and sterility testing to help ensure
the safety of various products and ingredients including
pharmaceuticals, cosmetics, personal care
products, vitamins, water, veterinary products, natural health
products, etc. All analysis are performed in compliance with cGMP
requirements using methods from relevant compendia and
pharmacopoeia.
 Our experienced microbiology team has expertise in a variety of
compendial assays, including:
 USP/NF
 AAMI
 BP/ Ph.Eur
 JP
 AOAC
 AWWA
 FDA
 Client supplied methods.

Neopharm Labs provides analytical testing services including chemistry, microbiology, sterility testing, and method development and validation to the pharmaceutical, biotech, cosmetic, and veterinary industries. It has over 110 employees and 32,000 square feet of facilities in Quebec, Canada. Neopharm is certified by the FDA and Health Canada and audited by global pharmaceutical companies. It has a wide range of instrumentation and offers services such as dissolution testing, stability studies, and microbiological assays.